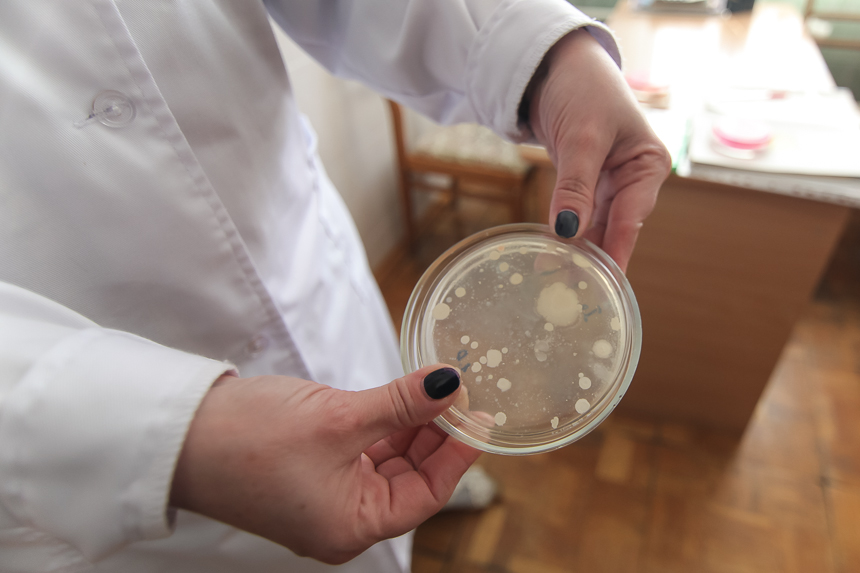
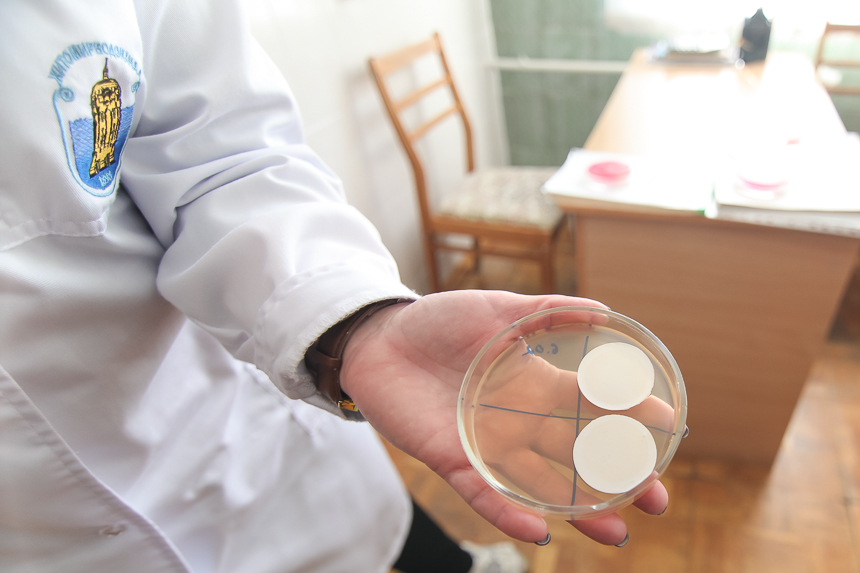

Сьогодні: Пн, 14.07.2025 06:00:59
| ЖЖ » Новини » Місто і життя » 2018 Февраль 7 » 15:22:25 |
Водоканал показал весь процесс очистки питьевой воды в Житомире. ФОТОРЕПОРТАЖ

Источником хозяйственно-питьевого водоснабжения Житомира является водозабор «Видсичне» на реке Тетерев. Это единственный источник водоснабжения в городе. Для накопления запаса воды и для регулирования уровня воды в водозаборе существует водохранилище «Деныши».
Система водоснабжения включает в себя подъем, водоподготовку и транспортировки питьевой воды потребителям. О том, как «готовят» питьевую воду в городе сообщает Житомир.info.
Качество питьевой воды должно соответствовать требованиям ГСанПиН 2.2.4-171-10 «Гигиенические требования к воде питьевой, предназначенной для потребления человеком». Питьевая вода отпускается для потребностей населения, коммунально-бытовых предприятий, городского хозяйства, хозяйственно-питьевых нужд промышленных предприятий и на тушение пожаров.
Очистка и подготовка питьевой воды в количестве 75 тыс. м3 в сутки осуществляется на сооружениях, расположенных на станциях I и II подъемов с последующей транспортировкой потребителям через распределительную водопроводную систему города с помощью четырех насосных станций III подъема, и малых повышающих насосных станций.
Предварительная очистка воды начинается уже на площадке I подъема и состоит из водоприемных сооружений: приемный оголовок с рыбозащитным устройством, водоприемные линии, береговой водоприемный колодец с сетками. Машинный зал, который подает воду на высокоскоростные фильтры, где очистка проходит через пакет сеток в 50 мкн. Далее вода хлорируется и по водоводам сырой воды d-1200 мм и d-600 мм поступает на очистные сооружения второго подъема.
Здесь очищают воду по двум технологиям. Первая технология водоподготовки работает с 1965 года. Это классическая схема: смесители, отстойники, фильтры. Эта технология называется двухступенчатая. В смесителе «вихревого» типа в «сырую» воду подаются реагенты: гипохлорит, коагулянт, флокулянт: гипохлорит для обеззараживания, коагулянт и флокулянт - для очистки воды. При этом мелкие, взвешенные части, содержащиеся в воде под действием коагулянтов и флокулянтов, образуют хлопья, которые выпадают в осадок в горизонтальных отстойниках. Время прохождения (отстаивание) воды в отстойнике - 2 часа. После чего, вода идет на блок фильтров, которые загружены фильтрующим материалом «Цеолитом». Отфильтрованная чистая вода еще раз хлорируется и поступает в резервуар чистой воды.



Фильтровальные залы





Здесь готовят флокулянт, ускоритель процесса коагуляции
Вторая технология водоподготовки построена и работает с 1982 года. Это одноступенчатая технология. Можно сказать, что это не очень удачный проект. Водоподготовка не имеет отстойников, а только контактные осветители. Для осветления воды коагулянт подается непосредственно в контактный осветлитель, который загружен кварцевым песком. При большой мутности такие очистные сооружения с очисткой воды не справляются. Все-таки должны быть отстойники со свободным объемом, где основное загрязнение воды с помощью реагентов пойдет в осадок.
Но после реконструкции блока контактных осветлителей в технологию были включены быстрые фильтры как дополнительный этап фильтрации. Данные фильтры загрузили цеолитом. Цеолит - это не только фильтрующий материал, но и сорбент, который накапливает вредные соединения: марганец, радионуклиды и др. Высота фильтрующего материала 1,80 м. После второго этапа фильтрации вода повторно хлорируется и поступает в резервуар чистой воды.








Промывка фильтра

После промывки
Качество воды постоянно контролируется как в водохранилище «Видсичне», так и на всех этапах очистки по 45-ти показателям.
Дозы реагентов и их расходы зависят от качества исходной воды, полученной из водохранилища «Видсичне», которая меняется от времени года, погоды, температуры воды и подбираются методом пробного хлорирования, коагуляции.

Вода до очистки

Вода после очистки
Вода после очистки
Обеззараживания воды - самый основной этап очистки, что гарантирует безопасность населения от епидемий. Контроль за хлорированием ведется ежечасно. Хлорирование имеет несколько точек ввода. Реагенты хлор и гипохлорит. Кроме того, придерживаются графика санитарно-профилактических мероприятий: промывка и дезинфекция резервуаров чистой воды и сети водопровода, которые проводятся не реже двух раз в год. График утверждается Госпродпотребслужбой.





Питьевую воду в сеть водопровода подают насосы, установленные в машинном зале
Когда были спроектированы и построены очистные сооружения, водохранилище «Видсичне» по показателям качества воды принадлежало к источнику водоснабжения I класса. И уже более десяти лет источник по некоторым показателям (гидробиологии, мутности, марганца, запаха, привкуса) относится к 3-4 классу. Поэтому встал вопрос по проектированию и строительству новых сооружений, которые справлялись бы с очисткой исходной воды такого низкого качества. На сегодня уже есть проект по новой технологии, которая будет отвечать следующим требованиям: технологическая, качественная, экологическая, экономическая. Строительство должно начаться в 2018 году.

Тэги:
Схожі новини:
Оголошення на ЖЖ інфо:

Который мы и наблюдаем из крана.